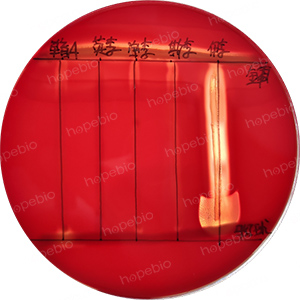
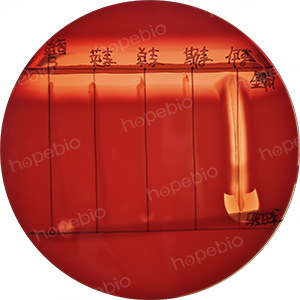

海博微信公众号
海博微信公众号
 海博天猫旗舰店
海博天猫旗舰店


 海博微信公众号
海博微信公众号
 海博天猫旗舰店
海博天猫旗舰店




一、试验简介
李斯特氏菌协同溶血试验(CAMP试验)是一种用于检测李斯特氏菌(特别是单增李斯特氏菌,Listeria monocytogenes)与其他细菌(如金黄色葡萄球菌或马红球菌)之间协同溶血作用的试验方法。该试验是鉴定李斯特氏菌的重要方法之一,尤其在区分致病性李斯特氏菌和非致病性菌株时非常重要。
二、试验原理
CAMP试验基于细菌溶血素之间的协同作用。单增李斯特氏菌能够产生一种称为李斯特菌溶血素O(LLO,Listeriolysin O)的毒素,这种毒素可以溶解红细胞。在CAMP试验中,单增李斯特氏菌与金黄色葡萄球菌(菌株ATCC 25923)共同培养时,金黄色葡萄球菌产生的β-溶血素会增强单增李斯特氏菌的溶血作用,从而在两种细菌的交界处形成明显的箭头状溶血区。马红球菌产生的胆固醇氧化酶也可以增强某些细菌溶血素的作用。
三、试验方法
1. 培养基制备:使用含5%-7%羊血或马血的血琼脂平板(HB8519-1 7%羊血琼脂基础+1001339-1 脱纤维羊血/HBPM6235 血平皿平板)。
2. 划线接种:在羊血琼脂平板上平行划线接种金黄色葡萄球菌(ATCC 25923)和马红球菌,挑取纯培养的单个可疑菌落垂直划线接种于平行线之间,垂直线两端不要触及平行线,距离1mm~2mm,同时接种单增李斯特氏菌、英诺克李斯特氏菌、伊氏李斯特氏菌和斯氏李斯特氏菌,于36℃±1℃培养24h~48h。
3. 观察两种细菌交界处的溶血现象。若结果不明显,可置4℃冰箱24h~48h后再观察。
四、结果判断
1. 单增李斯特氏菌在靠近金黄色葡萄球菌处出现约2mm的β-溶血增强区域,5%~8%的单增李斯特氏菌在马红球菌一端也有溶血增强现象;
2. 斯氏李斯特氏菌在靠近金黄色葡萄球菌处出现微弱的溶血增强区域;
3. 伊氏李斯特氏菌在靠近马红球菌处出现约5mm~10mm的“箭头状”β-溶血增强区域;
4. 英诺克李斯特氏菌不产生溶血现象。
接种菌株,放置于36℃±1℃需氧培养24h~48h,试验结果如图1所示。
图1 协同溶血试验结果
备注:单盲A:待测菌落;英李:英诺克李斯特氏菌ATCC 33090;单李:单增李斯特氏菌ATCC 19114;斯李:斯氏李斯特氏菌ATCC 35967;伊李:伊氏李斯特氏菌ATCC 19119;马红球:马红球菌CICC 22955;金葡:金黄色葡萄球菌ATCC 25923
五、注意事项
1. 使用新鲜的血琼脂培养基以确保红细胞活性。
2. 两种细菌的划线距离应适中(1mm-2mm),过近或过远可能影响结果。
3. 建议同时接种已知协同溶血阳性和阴性李斯特氏菌作为对照。
4. 协同菌株的选择:金黄色葡萄球菌必须使用菌株ATCC 25923,若使用其他金黄色葡萄球菌菌株,可能会影响单增李斯特氏菌协同溶血现象的观察,结果如图2所示。具体原因可参考往期原创文章:《细菌溶血试验原理及现象》。
图2 协同溶血试验结果
备注:单盲B:待测菌落;英李:英诺克李斯特氏菌ATCC 33090;单李:单增李斯特氏菌ATCC 19114;斯李:斯氏李斯特氏菌ATCC 35967;伊李:伊氏李斯特氏菌ATCC 19119;马红球:马红球菌CICC 22955;金葡:金黄色葡萄球菌ATCC 6538
注:本文属海博生物原创,未经允许不得转载。
下一篇:没有了!



